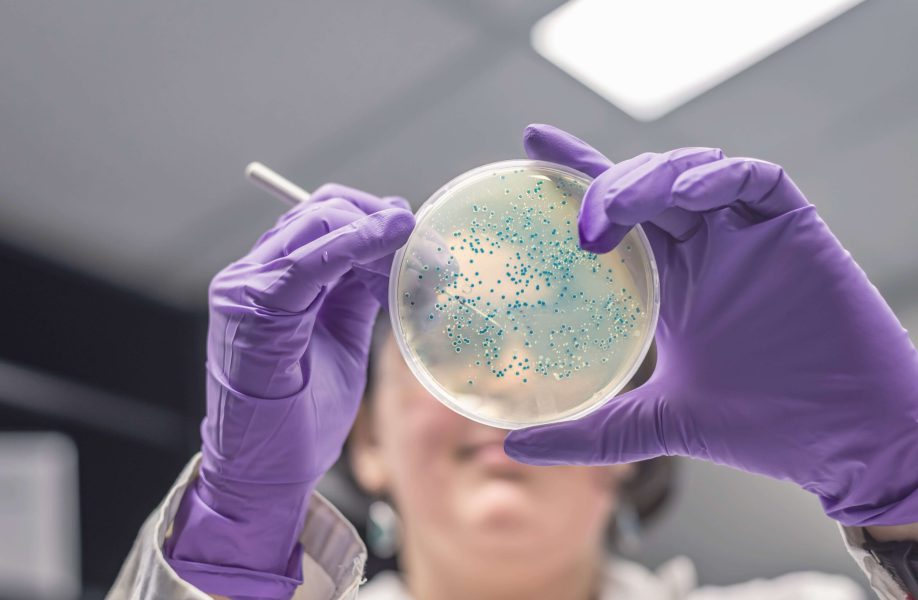
WeCan_Blog_Veterinario_57F

Antiguamente se hablaba de «flora intestinal», pero hoy sabemos que este término es incorrecto. Los microorganismos que habitan en el intestino no pertenecen al reino vegetal, sino que forman parte de lo que llamamos microbiota.
La microbiota es el conjunto de microorganismos (bacterias, hongos, virus, protozoos y arqueas) que colonizan distintas partes del cuerpo, como el intestino, la piel, el tracto respiratorio, el aparato genital y la conjuntiva. De todas ellas, la microbiota intestinal es la más numerosa y juega un papel clave en la salud de perros y gatos.
A su vez, el término microbioma hace referencia a la microbiota de una zona específica junto con su material genético y el microambiente que la rodea, como el sistema digestivo.
¿Es igual la microbiota en perros, gatos y humanos?
No. Aunque pueden tener ciertas similitudes, la microbiota de los perros, los gatos y los humanos es diferente. Cada especie tiene su propio equilibrio de microorganismos, adaptado a sus necesidades biológicas y ambientales.
Factores que alteran la microbiota intestinal en perros y gatos
El equilibrio de la microbiota puede alterarse por distintos factores, favoreciendo el crecimiento de microorganismos no deseados. Algunos de los principales desencadenantes son:
- Edad: con el paso del tiempo, la microbiota se deteriora de manera natural.
- Dieta: la alimentación juega un papel clave en el equilibrio intestinal.
- Uso prolongado de medicamentos: algunos fármacos pueden afectar negativamente la microbiota.
- Estrés: situaciones de ansiedad o cambios en el entorno pueden alterar el equilibrio de microorganismos.
- Vida sedentaria: la falta de actividad física influye en la salud digestiva.
- Enfermedades: algunas patologías pueden modificar la microbiota intestinal.
Funciones de la microbiota intestinal
La microbiota intestinal cumple numerosas funciones esenciales para la salud de los perros y gatos, entre ellas:
✔ Desarrollo del sistema gastrointestinal.
✔ Modulación del sistema inmunológico.
✔ Protección frente a patógenos externos.
✔ Mantenimiento de la barrera intestinal.
✔ Producción de metabolitos beneficiosos.
✔ Regulación del sistema nervioso.
Cómo cuidar la microbiota intestinal de tu peludo
Para mantener una microbiota equilibrada y saludable en tu perro o gato, es fundamental seguir estas recomendaciones:
- Dieta de calidad: proporciónale una dieta equilibrada, rica en fibra, proteína de alta calidad y grasas saludables.
- Evitar azúcares: no es recomendable dar alimentos procesados con azúcares añadidos.
- Probióticos y prebióticos: pueden ayudar a reforzar la microbiota intestinal.
- Reducir el estrés: evitar situaciones de ansiedad o cambios bruscos en su entorno.
- Ejercicio diario: favorece el equilibrio digestivo y la salud en general.
La microbiota intestinal es fundamental en la salud de perros y gatos. Su equilibrio influye en el sistema digestivo, inmunológico y nervioso, por lo que es importante cuidarla a través de una alimentación adecuada, probióticos, reducción del estrés y ejercicio. Aplicando estos cuidados, garantizarás el bienestar de tu peludo y mejorarás su calidad de vida.